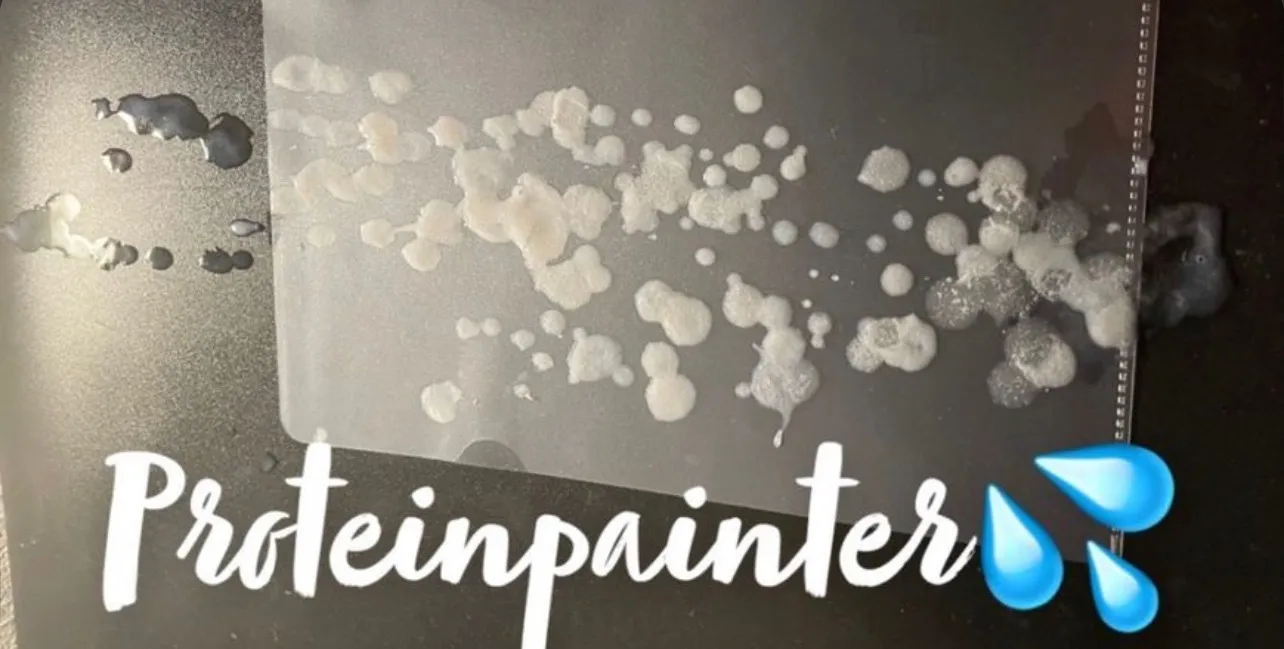
Proteinpainter OnlyFans header

Proteinpainter OnlyFans Stats
2
Videos
2
Posts
28
Likes
2
Media
About Proteinpainter OnlyFans
Professional cummer with a high libido who shoots protein on pics. Taking paid requests on Onlyfans💦
What You Get with Proteinpainter's OnlyFans
2 Videos
Exclusive video content
Direct Messaging
Chat directly with Proteinpainter
Exclusive Content
Content you won't find anywhere else
Proteinpainter OnlyFans FAQ
Is Proteinpainter's OnlyFans free?
Yes! Proteinpainter's OnlyFans is completely free to subscribe. You can follow them and view their free content without paying. They may also offer premium paid content through pay-per-view messages or tips.
How many photos and videos does Proteinpainter post?
Proteinpainter currently has
2 videos on their OnlyFans, across 2 posts. New content is added regularly.
How do I subscribe to Proteinpainter on OnlyFans?
- Click the "Subscribe Free on OnlyFans" button above
- Create an OnlyFans account or log in
- Click "Subscribe" on Proteinpainter's profile
- Enjoy their free content instantly!
Subscribe Free
✅ Free to subscribe
Is this your profile?
Claim This ProfileGallery
Profile Info
Username
propainterv2
Verified
No
Price
Free
Total Posts
2
Similar OnlyFans Creators You Might Like
Discover more creators
People Also Search For
Proteinpainter OnlyFans Profile — OnlyFinds
Looking for Proteinpainter OnlyFans? You've found the right place. OnlyFinds is the #1 OnlyFans search engine and creator directory. Browse Proteinpainter's full profile including bio, stats, subscription price, and social media links. Discover more creators like Proteinpainter on OnlyFinds.